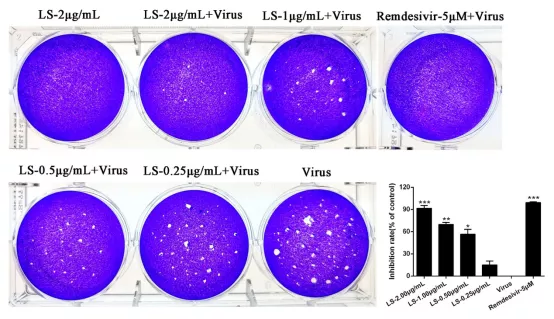

4月21日,国家呼吸系统疾病临床医学研究中心、广州呼吸健康研究院、呼吸疾病国家重点实验室杨子峰课题组研究论文Liu Shen capsule shows antiviral and anti-inflammatory abilities against novel coronavirus SARS-CoV-2 via suppression of NF-κB signaling pathway in vitro被国际药理期刊Pharmacological Research(IF5.574)接收。本论文发现六神胶囊(丸)可在细胞中抑制SARS-CoV-2病毒复制及其诱导的炎症因子表达,作用机理为抑制NF-κB p65、IκBα和MAPK p38等激酶的磷酸化,同时上调IκBα蛋白的表达,研究成果为六神胶囊(丸)用于COVID-19的临床治疗提供依据。杨子峰研究员为本文通讯作者,广州呼研院马钦海、潘蔚绮和李润峰博士为并列第一作者。
SARS-CoV-2通过人与人的接触在全球范围内传播,引起了国际社会广泛关注,急需有效抗病毒治疗方法。六神胶囊(丸)源自苏州雷允上诵芬堂方,迄今已逾150年历史,是传统温病学派治疗疫病的重要代表方剂,具有抗炎、抗病毒、免疫调节等多种药理作用。在历次疫病爆发防治中都发挥了重要作用,受到众多名家的推荐用于治疗疫病。六神胶囊(丸)已被21个国家指南、共识、诊疗方案推荐用于SARS、感冒、流感等呼吸疾病的治疗,其治疗H1N1流感药效研究新近发表在SCI期刊Journal of Ethnopharmacology。六神胶囊(丸)已被列入广州医科大学、上海、河北等省《新型冠状病毒感染的肺炎诊疗方案》。
杨子峰团队发现,六神胶囊(丸)能显著抑制SARS-CoV-2在Vero E6细胞中的复制,IC50(半数有效浓度)为0.6024μg/mL,可减少胞浆、胞内囊泡和细胞膜表面的病毒颗粒数量,并能在mRNA水平上显著减少促炎细胞因子(TNF-α、IL-6、IL-1β、IL-8、CCL-2/MCP-1和CXCL-10/IP-10)的产生。
图1 六神胶囊(LS)对SARS-CoV-2在Vero E6细胞的复制显示出抑制作用

图2 六神胶囊(LS)抑制SARS-CoV-2感染Huh-7细胞诱导的炎症因子mRNA表达

图3 六神胶囊(LS)抑制SARS-CoV-2感染Huh-7细胞引起的NF-κB和MAPK p38信号通路表达
该研究得到广东省科技创新战略专项资金(广东省防控新型冠状病毒感染科技攻关应急专项)的资助。